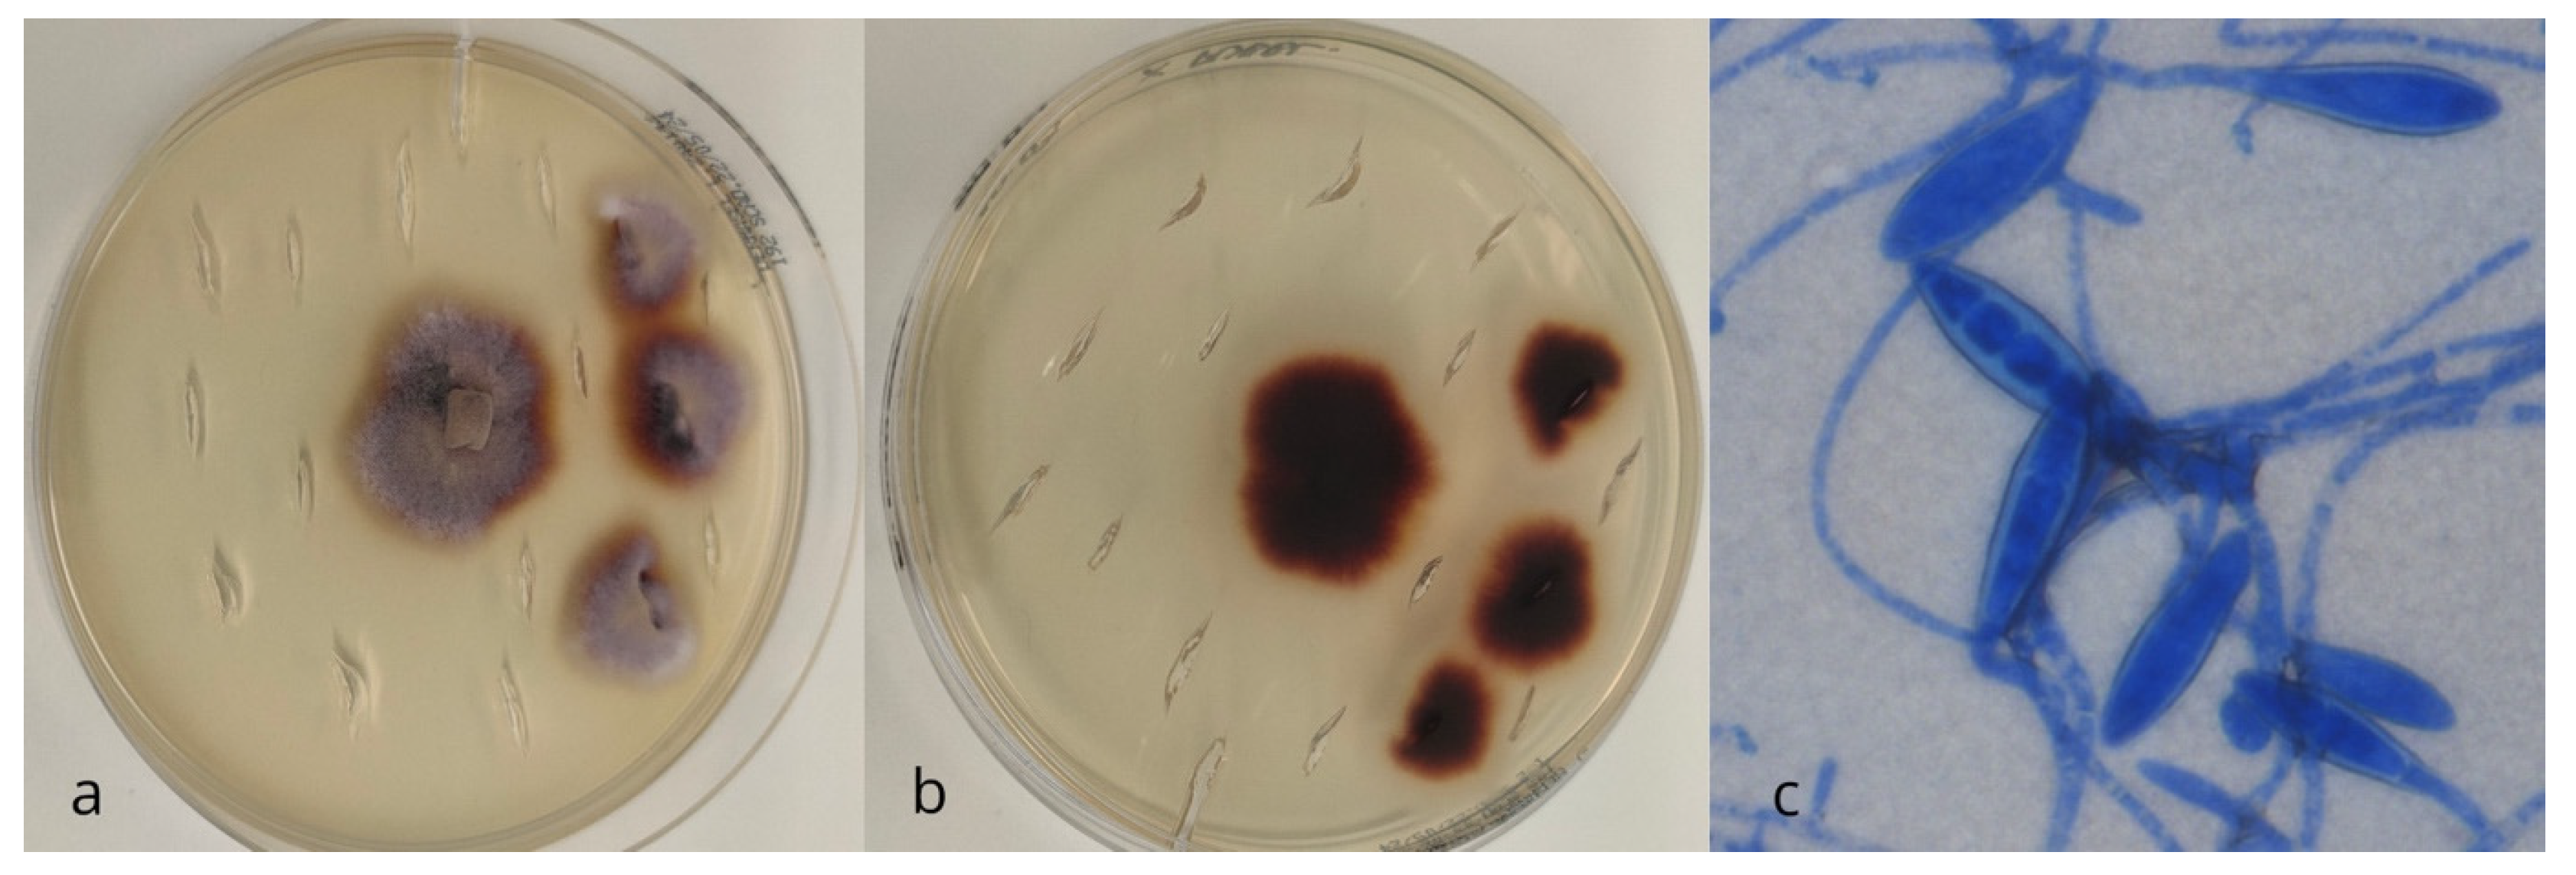
Vetsci 12 00306 g001 Vetsci 12 00306 g001

Mycological Survey and Antifungal Susceptibility Evaluation of Candida albicans Isolates in European Hedgehogs (Erinaceus europaeus)
Simple Summary
Abstract
1. Introduction
2. Materials and Methods
3. Results
4. Discussion
Author Contributions
Funding
Institutional Review Board Statement
Informed Consent Statement
Data Availability Statement
Acknowledgments
Conflicts of Interest
References
- Mitchell-Jones, A.J.; Amori, G.; Bogdanowicz, W.; Krystufek, B.; Reijnders, P.J.H.; Spitzenberger, F.; Stubbe, M.; Thissen, J.B.M.; Vohralik, V.; Zima, J. The Atlas of European Mammals; PR Academy Ltd.: London, UK, 1999. [Google Scholar]
- Rasmussen, S.L.; Berg, T.B.; Dabelsteen, T.; Jones, O.R. The ecology of suburban juvenile European hedgehogs (Erinaceus europaeus) in Denmark. Ecol. Evol. 2019, 9, 13174–13187. [Google Scholar] [CrossRef]
- Rondinini, C.; Doncaster, C.P. Roads as barriers to movement for hedgehogs. Funct. Ecol. 2002, 16, 504–509. [Google Scholar] [CrossRef]
- Mariacher, A.; Santini, A.; Del Lesto, I.; Tonon, S.; Cardini, E.; Barone, A.; Eleni, C.; Fichi, G.; Perrucci, S. Endoparasite Infections of the European Hedgehog (Erinaceus europaeus) in Central Italy. Animals 2021, 11, 3171. [Google Scholar] [CrossRef]
- Gaglio, G.; Allen, S.; Bowden, L.; Bryant, M.; Morgan, E.R. Parasites of European hedgehogs (Erinaceus europaeus) in Britain: Epidemiological study and coprological test evaluation. Eur. J. Wildl. Res. 2010, 56, 839–844. [Google Scholar] [CrossRef]
- Rasmussen, S.L.; Hallig, J.; van Wijk, R.E.; Petersen, H.H. An investigation of endoparasites and the determinants of parasite infection in European hedgehogs (Erinaceus europaeus) from Denmark. Int. J. Parasitol. Parasites Wildl. 2021, 16, 217–227. [Google Scholar] [CrossRef]
- Dyachenko, V.; Kuhnert, Y.; Schmaeschke, R.; Etzold, M.; Pantchev, N.; Daugschies, A. Occurrence and molecular characterization of Cryptosporidium spp. genotypes in European hedgehogs (Erinaceus europaeus L.) in Germany. Parasitology 2010, 137, 205–216. [Google Scholar] [CrossRef] [PubMed]
- Krawczyk, A.I.; van Leeuwen, A.D.; Jacobs-Reitsma, W.; Wijnands, L.M.; Bouw, E.; Jahfari, S.; van Hoek, A.H.A.M.; van der Giessen, J.W.B.; Roelfsema, J.H.; Kroes, M.; et al. Presence of zoonotic agents in engorged ticks and hedgehog faeces from Erinaceus europaeus in (sub)urban areas. Parasit. Vectors 2015, 8, 210. [Google Scholar] [CrossRef]
- Ruszkowski, J.J.; Hetman, M.; Turlewicz-Podbielska, H.; Pomorska-Mól, M. Hedgehogs as a Potential Source of Zoonotic Pathogens—A Review and an Update of Knowledge. Animals 2021, 11, 1754. [Google Scholar] [CrossRef]
- Garcias, B.; Aguirre, L.; Seminati, C.; Reyes, N.; Allepuz, A.; Obón, E.; Molina-Lopez, R.A.; Darwich, L. Extended-Spectrum β-Lactam Resistant Klebsiella pneumoniae and Escherichia coli in Wild European Hedgehogs (Erinaceus europeus) Living in Populated Areas. Animals 2021, 11, 2837. [Google Scholar] [CrossRef]
- Gnat, S.; Łagowski, D.; Dyląg, M.; Nowakiewicz, A. European Hedgehogs (Erinaceus europaeus L.) as a Reservoir of Dermatophytes in Poland. Microb. Ecol. 2022, 84, 363–375. [Google Scholar] [CrossRef]
- Le Barzic, C.; Cmokova, A.; Denaes, C.; Arné, P.; Hubka, V.; Guillot, J.; Risco-Castillo, V. Detection and Control of Dermatophytosis in Wild European Hedgehogs (Erinaceus europaeus) Admitted to a French Wildlife Rehabilitation Centre. J. Fungi 2021, 7, 74. [Google Scholar] [CrossRef] [PubMed]
- de Hoog, G.S.; Dukik, K.; Monod, M.; Packeu, A.; Stubbe, D.; Hendrickx, M.; Kupsch, C.; Stielow, J.B.; Freeke, J.; Göker, M.; et al. Toward a Novel Multilocus Phylogenetic Taxonomy for the Dermatophytes. Mycopathologia 2017, 182, 5–31. [Google Scholar] [CrossRef]
- Gnat, S.; Łagowski, D.; Nowakiewicz, A.; Osińska, M.; Kopiński, Ł. Population Differentiation, Antifungal Susceptibility, and Host Range of Trichophyton mentagrophytes Isolates Causing Recalcitrant Infections in Humans and Animals. Eur. J. Clin. Microbiol. Infect. Dis. 2020, 39, 2099–2113. [Google Scholar] [CrossRef]
- Marples, M.J.; Smith, J.M.B. The Hedgehog as a Source of Human Ringworm. Nature 1960, 188, 867–868. [Google Scholar] [CrossRef] [PubMed]
- Concha, M.; Nicklas, C.; Balcells, E.; Guzmán, A.M.; Poggi, H.; León, E.; Fich, F. The First Case of Tinea Faciei Caused by Trichophyton mentagrophytes var. erinacei Isolated in Chile. Int. J. Dermatol. 2012, 51, 283–285. [Google Scholar] [CrossRef]
- Lee, D.; Yang, J.; Choi, S.; Won, C.; Chang, S.; Lee, M.; Choi, J.; Moon, K.; Kim, M. An Unusual Clinical Presentation of Tinea Faciei Caused by Trichophyton mentagrophytes var. erinacei. Pediatr. Dermatol. 2011, 28, 210–212. [Google Scholar] [CrossRef]
- Nenoff, P.; Herrmann, J.; Gräser, Y. Trichophyton mentagrophytes sive interdigitale? A Dermatophyte in the Course of Time. JDDG J. Dtsch. Dermatol. Ges. 2007, 5, 198–202. [Google Scholar] [CrossRef]
- Fairley, R.A. The Histological Lesions of Trichophyton mentagrophytes var. erinacei Infection in Dogs. Vet. Dermatol. 2001, 12, 119–122. [Google Scholar] [CrossRef] [PubMed]
- Kurtdede, A.; Haydardedeoglu, A.E.; Alihosseini, H.; Colakoglu, E.C. Dermatophytosis Caused by Trichophyton mentagrophytes var. erinacei in a Dog: A Case Report. Vet. Med. 2014, 59, 349–351. [Google Scholar] [CrossRef]
- Iacob, O.; Iftinca, A. The Dermatitis by Caparinia tripilis and Microsporum, in African Pygmy Hedgehog (Atelerix albiventris) in Romania–First Report. Rev. Bras. Parasitol. Vet. 2018, 27, 584–588. [Google Scholar] [CrossRef]
- Smith, J.M.B.; Marples, M.J. Trichophyton mentagrophytes var. erinacei. Med. Mycol. 1964, 3, 1–10. [Google Scholar] [CrossRef]
- Barlow, A.; Partridge, T.; Clark, C.; Everest, D. Oral Candidiasis in European Hedgehogs. Vet. Rec. 2012, 171, 602–603. [Google Scholar] [CrossRef] [PubMed]
- Campbell, T. Intestinal Candidiasis in an African Hedgehog (Atelerix albiventris). Exot. Pet Pract. 1997, 2, 79. [Google Scholar]
- Moriello, K.A. Diagnostic techniques for dermatophytosis. Clin. Tech. Small Anim. Pract. 2001, 16, 219–224. [Google Scholar] [CrossRef]
- Ngo, T.M.C.; Ton Nu, P.A.; Le, C.C.; Ha, T.N.T.; Do, T.B.T.; Tran Thi, G. First Detection of Trichophyton indotineae Causing Tinea Corporis in Central Vietnam. Med. Mycol. Case Rep. 2022, 36, 37–41. [Google Scholar] [CrossRef] [PubMed]
- Hall, T.A. BioEdit: A User-Friendly Biological Sequence Alignment Editor and Analysis Program for Windows 95/98/NT. Nucleic Acids Symp. Ser. 1999, 41, 95–98. [Google Scholar]
- CLSI. Clinical and Laboratory Standards Institute. In Performance Standards for Antifungal Susceptibility Testing of Yeasts, 1st ed.; CLSI: Malvern, PA, USA, 2017. [Google Scholar]
- Xiao, J.L.; Xu, G.C.; de Hoog, S.; Qiao, J.J.; Fang, H.; Li, Y.L. Oral Prevalence of Candida Species in Patients Undergoing Systemic Glucocorticoid Therapy and the Antifungal Sensitivity of the Isolates. Infect. Drug Resist. 2020, 13, 2601–2607. [Google Scholar] [CrossRef]
- Daniel, H.-M.; Lachance, M.-A.; Kurtzman, C.P. On the Reclassification of Species Assigned to Candida and Other Anamorphic Ascomycetous Yeast Genera Based on Phylogenetic Circumscription. Antonie Van Leeuwenhoek 2014, 106, 67–84. [Google Scholar] [CrossRef]
- Abarca, M.L.; Castellá, G.; Martorell, J.; Cabañes, F.J. Trichophyton erinacei in Pet Hedgehogs in Spain: Occurrence and Revision of Its Taxonomic Status. Med. Mycol. 2017, 55, 164–172. [Google Scholar] [CrossRef]
- Čmoková, A.; Kolařík, M.; Guillot, J.; Risco-Castillo, V.; Cabañes, F.J.; Nenoff, P.; Uhrlaß, S.; Dobiáš, R.; Mallátová, N.; Yaguchi, T.; et al. Host-driven subspeciation in the hedgehog fungus, Trichophyton erinacei, an emerging cause of human dermatophytosis. Persoonia 2022, 48, 203–218. [Google Scholar] [CrossRef]
- Takahashi, Y.; Sano, A.; Takizawa, K.; Fukushima, K.; Miyaji, M.; Nishimura, K. The epidemiology and mating behavior of Arthroderma benhamiae var. erinacei in household four-toed hedgehogs (Atelerix albiventris) in Japan. Nippon Ishinkin Gakkai Zasshi 2003, 44, 31–38. [Google Scholar] [CrossRef][Green Version]
- Illner, A.; Michl, C.; Sunderkötter, C.; Uhrlaß, S.; Krüger, C.; Baert, F.; Stubbe, D.; Nenoff, P. Paraphyton mirabile-A rare geophilic derma-tophyte-with unclear relation to nail disease. J. Eur. Acad. Dermatol. Venereol. 2023, 27, E991–E993. [Google Scholar] [CrossRef]
- Pal, M. Rhodotoruliosis: An Emerging Opportunistic Mycosis of Humans and Animals. Open Access J. Mycol. Mycol. Sci. 2021, 4. [Google Scholar] [CrossRef]
- Pfaller, M.A.; Diekema, D.J.; Mendez, M.; Kibbler, C.; Erzsebet, P.; Chang, S.-C.; Gibbs, D.L.; Newell, V.A. Candida guilliermondii, an Opportunistic Fungal Pathogen with Decreased Susceptibility to Fluconazole: Geographic and Temporal Trends from the ARTEMIS DISK Antifungal Surveillance Program. J. Clin. Microbiol. 2006, 44, 3551–3556. [Google Scholar] [CrossRef] [PubMed]
- D’Havé, H.; Scheirs, J.; Verhagen, R.; De Coen, W. Gender, age and seasonal dependent self-anointing in the European hedgehog Erinaceus europaeus. Acta Theriol. 2005, 50, 167–173. [Google Scholar] [CrossRef]
- Begum, J.; Kumar, R. Prevalence of Dermatophytosis in Animals and Antifungal Susceptibility Testing of Isolated Trichophyton and Microsporum Species. Trop. Anim. Health Prod. 2021, 53, 3. [Google Scholar] [CrossRef]
- Yurayart, C.; Niae, S.; Limsivilai, O.; Thengchaisri, N.; Sattasathuchana, P. Comparative Analysis of the Distribution and Antifungal Susceptibility of Yeast Species in Cat Facial Hair and Human Nails. Sci. Rep. 2024, 14, 14726. [Google Scholar] [CrossRef]
- Marenzoni, M.L.; Morganti, G.; Moretta, I.; Crotti, S.; Agnetti, F.; Moretti, A.; Pitzurra, L.; Casagrande Proietti, P.; Sechi, P.; Cenci Goga, B.; et al. Microbiological and parasitological survey of zoonotic agents in apparently healthy feral pigeons. Pol. J. Vet. Sci. 2016, 19, 309–315. [Google Scholar] [CrossRef]
- Pascucci, I.; Antognini, E.; Canonico, C.; Montalbano, M.G.; Necci, A.; di Donato, A.; Moriconi, M.; Morandi, B.; Morganti, G.; Crotti, S.; et al. One Health Approach to Rickettsiosis: A Five-Year Study on Spotted Fever Group Rickettsiae in Ticks Collected from Humans, Animals and Environment. Microorganisms 2022, 10, 35. [Google Scholar] [CrossRef]
- Musa, L.; Stefanetti, V.; Casagrande Proietti, P.; Grilli, G.; Gobbi, M.; Toppi, V.; Brustenga, L.; Magistrali, C.F.; Franciosini, M.P. Antimicrobial Susceptibility of Commensal E. coli Isolated from Wild Birds in Umbria (Central Italy). Animals 2023, 13, 1776. [Google Scholar] [CrossRef]
- López-Islas, J.J.; Méndez-Olvera, E.T.; Reyes, C.T.; Martínez-Gómez, D. Identification of Antimicrobial Resistance Genes in Intestinal Content from Coyote (Canis latrans). Pol. J. Vet. Sci. 2023, 26, 143–149. [Google Scholar] [CrossRef] [PubMed]
- Rhimi, W.; Sgro, G.; Aneke, C.I.; Annoscia, G.; Latrof, M.S.; Mosca, A.; Venezian, V.; Otranto, D.; Alastruey-Izquierdo, A.; Cafarchia, C. Wild Boar (Sus scrofa) as Reservoir of Zoonotic Yeasts: Bioindicator of Environmental Quality. Mycopathologia 2022, 187, 235–248. [Google Scholar] [PubMed]
- Jota Baptista, C.V.; Seixas, F.; Gonzalo-Orden, J.M.; Oliveira, P.A. Can the European Hedgehog (Erinaceus europaeus) Be a Sentinel for One Health Concerns? Biologics 2021, 1, 61–69. [Google Scholar] [CrossRef]

| Paraphyton mirabile Positives/ Total Samples (%) | Candida albicans Positives/ Total Samples (%) | Yarrowia lipolytica Positives/ Total Samples (%) | Rhodotorula mucilaginosa Positives/ Total Samples (%) | Meyerozyma guilliermondii Positives/ Total Samples (%) | |
|---|---|---|---|---|---|
| Toothbrush | 1/134 (0.8%) | 0/134 | 0/134 | 0/134 | 0/134 |
| Oral swab | Na | 12/86 * (14.0%) | 0/86 | 1/86 (1.16%) | 1/86 (1.16%) |
| Rectal swab | Na | 9/86 * (10.47%) | 2/86 (2.33%) | 0/86 | 0/86 |
| N° of isolates | 1 | 21 | 2 | 1 | 1 |
| Candida albicans (n. Isolates = 21) | Isolates | NDF | MCF | CSP | FCT | POS | VOR | ITR | FLU | AMB |
| Sensitivity RANGE | 0.015–2 | 0.008–2 | 0.008–2 | 0.06–4 | 0.008–1 | 0.008–1 | 0.015–0.12 | 0.12–8 | 0.12–1 | |
| MIC | Isolate 01 | 0.015 | 0.015 | 0.03 | 0.12 | 0.03 | 0.015 | 0.03 | 0.25 | 0.25 |
| Isolate 02 | 0.015 | 0.015 | 0.06 | 0.12 | 0.015 | 0.015 | 0.03 | 0.25 | 0.25 | |
| Isolate 03 | 0.015 | 0.015 | 0.06 | 0.12 | 0.015 | 0.015 | 0.03 | 0.25 | 0.25 | |
| Isolate 04 | 0.015 | 0.015 | 0.06 | 0.12 | 0.015 | 0.015 | 0.03 | 0.5 | 0.25 | |
| Isolate 05 | 0.015 | 0.03 | 0.03 | 0.25 | 0.015 | 0.008 | 0.03 | 0.25 | 0.25 | |
| Isolate 06 | 0.03 | 0.015 | 0.03 | 0.25 | 0.015 | 0.015 | 0.03 | 0.25 | 0.25 | |
| Isolate 07 | 0.015 | 0.008 | 0.03 | 0.06 | 0.03 | 0.015 | 0.06 | 0.25 | 0.25 | |
| Isolate 08 | 0.015 | 0.008 | 0.06 | 0.06 | 0.03 | 0.008 | 0.06 | 0.5 | 0.25 | |
| Isolate 09 | 0.015 | 0.015 | 0.06 | 0.06 | 0.015 | 0.008 | 0.12 | 0.25 | 0.25 | |
| Isolate 10 | 0.015 | 0.015 | 0.06 | 0.06 | 0.03 | 0.015 | 0.06 | 0.25 | 0.25 | |
| Isolate 11 | 0.015 | 0.015 | 0.06 | 0.06 | 0.03 | 0.015 | 0.06 | 0.25 | 0.25 | |
| Isolate 12 | 0.015 | 0.015 | 0.03 | 0.12 | 0.03 | 0.015 | 0.06 | 0.25 | 0.25 | |
| Isolate 13 | 0.015 | 0.015 | 0.03 | 0.12 | 0.03 | 0.015 | 0.06 | 0.25 | 0.25 | |
| Isolate 14 | 0.015 | 0.015 | 0.03 | 0.06 | 0.03 | 0.015 | 0.06 | 0.25 | 0.25 | |
| Isolate 15 | 0.015 | 0.015 | 0.03 | 0.12 | 0.03 | 0.015 | 0.06 | 0.5 | 0.25 | |
| Isolate 16 | 0.015 | 0.015 | 0.015 | 0.12 | 0.03 | 0.015 | 0.06 | 0.5 | 0.25 | |
| Isolate 17 | 0.03 | 0.008 | 0.03 | 0.06 | 0.03 | 0.008 | 0.03 | 0.25 | 0.25 | |
| Isolate 18 | 0.015 | 0.015 | 0.06 | 0.06 | 0.03 | 0.008 | 0.03 | 0.25 | 0.25 | |
| Isolate 19 | 0.015 | 0.015 | 0.06 | 0.06 | 0.03 | 0.008 | 0.03 | 0.25 | 0.25 | |
| Isolate 20 | 0.015 | 0.015 | 0.06 | 0.06 | 0.03 | 0.008 | 0.03 | 0.25 | 0.5 | |
| Isolate 21 | 0.015 | 0.015 | 0.03 | 0.06 | 0.03 | 0.015 | 0.06 | 0.25 | 0.25 | |
| MICm | 0.02 | 0.01 | 0.04 | 0.10 | 0.03 | 0.01 | 0.05 | 0.30 | 0.26 |
Disclaimer/Publisher’s Note: The statements, opinions and data contained in all publications are solely those of the individual author(s) and contributor(s) and not of MDPI and/or the editor(s). MDPI and/or the editor(s) disclaim responsibility for any injury to people or property resulting from any ideas, methods, instructions or products referred to in the content. |
© 2025 by the authors. Licensee MDPI, Basel, Switzerland. This article is an open access article distributed under the terms and conditions of the Creative Commons Attribution (CC BY) license (https://creativecommons.org/licenses/by/4.0/).
Share and Cite
Brustenga, L.; Morganti, G.; Gobbi, M.; Ranucci, A.; Rigamonti, G.; Moretta, I.; Diaferia, M.; D’Avino, N.; Cruciani, D.; Ciullo, M.; et al. Mycological Survey and Antifungal Susceptibility Evaluation of Candida albicans Isolates in European Hedgehogs (Erinaceus europaeus). Vet. Sci. 2025, 12, 306. https://doi.org/10.3390/vetsci12040306
Brustenga L, Morganti G, Gobbi M, Ranucci A, Rigamonti G, Moretta I, Diaferia M, D’Avino N, Cruciani D, Ciullo M, et al. Mycological Survey and Antifungal Susceptibility Evaluation of Candida albicans Isolates in European Hedgehogs (Erinaceus europaeus). Veterinary Sciences. 2025; 12(4):306. https://doi.org/10.3390/vetsci12040306
Chicago/Turabian StyleBrustenga, Leonardo, Giulia Morganti, Marco Gobbi, Alice Ranucci, Giulia Rigamonti, Iolanda Moretta, Manuela Diaferia, Nicoletta D’Avino, Deborah Cruciani, Marcella Ciullo, and et al. 2025. "Mycological Survey and Antifungal Susceptibility Evaluation of Candida albicans Isolates in European Hedgehogs (Erinaceus europaeus)" Veterinary Sciences 12, no. 4: 306. https://doi.org/10.3390/vetsci12040306
APA StyleBrustenga, L., Morganti, G., Gobbi, M., Ranucci, A., Rigamonti, G., Moretta, I., Diaferia, M., D’Avino, N., Cruciani, D., Ciullo, M., Massacci, F. R., & Crotti, S. (2025). Mycological Survey and Antifungal Susceptibility Evaluation of Candida albicans Isolates in European Hedgehogs (Erinaceus europaeus). Veterinary Sciences, 12(4), 306. https://doi.org/10.3390/vetsci12040306

